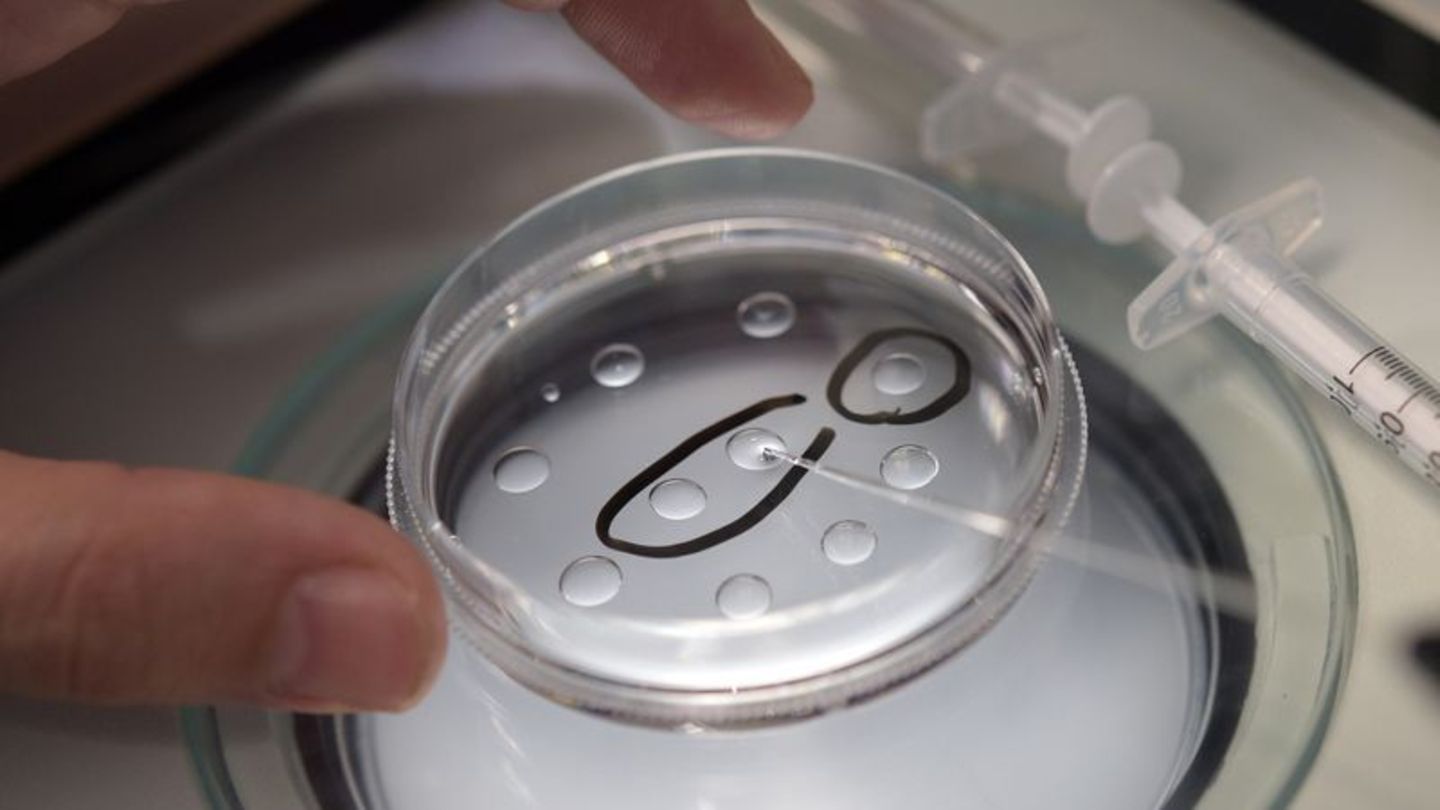

In Kinderwunschkliniken bundesweit suchen immer mehr ältere Frauen Hilfe - doch ihre Chancen sind oft relativ gering. Waren es 2011 noch rund 8000 Frauen aus dieser Altersgruppe, lag die Zahl zehn Jahre später bereits bei mehr als 12.600 Patientinnen. "Die Zahlen steigen nicht exorbitant, aber es ist ein Trend zu spüren", sagt Andreas Tandler-Schneider, Vorstandsmitglied im Deutschen IVF-Register, das Daten über Behandlungen aus mehr als 130 Kinderwunschzentren bundesweit zusammenträgt.
Oft seien die Frauen überrascht darüber, wie schlecht die Aussichten auf ein Baby trotz reproduktionsmedizinscher Hilfe seien. Ab 40 sinke nicht nur die Schwangerschaftsrate, die Fehlgeburtenrate nehme auch stark zu. "Die etwa 10 bis 20 Prozent Frauen, die pro Embryotransfer schwanger werden, verlieren die Kinder zu 50 Prozent wieder", so Tandler-Schneider. "Viele haben auch einfach unrealistische Erwartungen an die Reproduktionsmedizin."
Gynäkologe: "Generelles Phänomen in unserer Gesellschaft"
Doch woran liegt es, dass sich immer mehr Frauen erst spät einen Kinderwunsch erfüllen wollen? Aus Sicht des Gynäkologen Tandler-Schneider ist es ein "generelles Phänomen in unserer Gesellschaft, dass wir uns jünger fühlen als wir sind." Die Eierstockreserve gehe diesen Weg aber nicht mit. "Wir werden immer älter, bleiben länger fit, aber es ist nicht zu sehen, dass die Frauen später in die Wechseljahre kommen."
Bei vielen Paaren überwiege zunächst der Wunsch, das Leben ohne Kinder zu gestalten und Karriere zu machen. Vor allem in Großstädten sei das zu beobachten. "Hier ist der Akademikeranteil relativ hoch und viele Paare beschäftigen sich relativ spät mit dem Kinderwunsch." Tandler-Schneider, Arzt am Berliner Fertility Center, sieht einen "Zielkonflikt" in der Gesellschaft zwischen Kinderwunsch und gleichzeitig mangelnder Bereitschaft, diesen zu realisieren.
Eine immer größere Beteiligung von Frauen am Arbeitsmarkt, lange Ausbildungszeiten oder auch wirtschaftliche Unsicherheiten zu Beginn des Berufslebens seien nur einige Gründe für den aufgeschobenen Kinderwunsch, ergänzt Jasmin Passet-Wittig vom Bundesinstitut für Bevölkerungsforschung in Wiesbaden.
Forscherin: "Kinderlosigkeit akzeptierter"
"Auch der Aspekt, dass man auch einen passenden Partner braucht, wird oft vernachlässigt", so die Forscherin. "Hohe Scheidungsraten deuten darauf hin, dass selbst Ehen instabiler sind als früher. Es wird überhaupt schwieriger, einen Partner zu finden, der auch ein Kind will, da Kinderlosigkeit akzeptierter ist."
"Viele Menschen haben das Gefühl, dass keine Grenze mehr gesetzt ist für das Alter, in dem man Kinder bekommen kann", sagt Sonja Indira Steinert, Patientenbetreuerin bei der Kinderwunsch-Beratungsplattform Fertilly.com. Vor allem nach Medienberichten über Promis, die noch sehr spät Kinder bekommen haben, sei das Aufkommen an Anrufen besonders hoch. "Doch Schwangerschaften wie die der Promis entstehen oftmals mit Methoden, die in Deutschland nicht erlaubt sind - etwa durch Eizellspenden."
Patientenbetreuerin: "Augen vor Erfolgschancen verschlossen"
"Leider sind relevante Statistiken weitgehend unbekannt oder aber es werden die Augen vor den Erfolgschancen verschlossen. Der Kinderwunsch ist so groß, da wird alles andere ausgeblendet", sagt Steinert. Aus ihrer Sicht mangelt es häufig schon an grundlegendem Wissen über die Fruchtbarkeit.
"Schon in der Schulbildung liegt eine große Fehlerquelle, da geht es ja hauptsächlich um die Verhütung von Schwangerschaften, wodurch ein völlig unrealistisches Bild von Fruchtbarkeit entsteht", meint Steinert. Das teils mangelnde Wissen ziehe sich durch alle Schichten der Gesellschaft. Ein weiteres Problem sei, dass Kinderwunschbehandlungen noch immer ein großes Tabuthema seien und viele späte Eltern nicht darüber sprächen, auf welche Art und Weise sie ein Kind bekommen hätten. Auch das trage nicht zur Aufklärung bei.
Weil sie jahrelang vertröstet wurden oder der Partner fehlt, entscheiden sich laut Tandler-Schneider zunehmend auch Single-Frauen, ihren Kinderwunsch mit einer Samenspende allein zu realisieren, bevor es zu spät ist. "Früher gab es Sorgen seitens der Reproduktionsmediziner, doch diese hat man jetzt ausräumen können, da die Entwicklung der Kinder laut der bisherigen Forschung unauffällig ist und man den Patientinnen den Kinderwunsch nicht absprechen kann."
Und dann seien da noch die Frauen um die 30, die Eizellen einfrieren lassen, um später damit schwanger zu werden. "Sie kaufen sich praktisch eine Versicherung, dass es nach 40 auch noch funktionieren wird. Doch das ist eine Pseudosicherheit", sagt der Arzt. Die Erfolge beim Social Freezing seien mit etwa 20 Prozent nicht so hoch wie mit frischen Eizellen, wo die Erfolgsquote über alle Altersgruppen bei etwa 31 Prozent liege, so Tandler-Schneider. Auch fehle es noch an Erfahrungswerten. In Deutschland seien relativ viele Eizellen eingefroren - aber nur wenige wieder eingesetzt worden.
Kinder von älteren Eltern besser in der Schule
Gelingt der späte Kinderwunsch mit Ende 30, Anfang 40 doch noch, hat das aus Sicht des Wissenschaftlers Mikko Myrskylä vom Rostocker Max-Planck-Institut für demografische Forschung eine Menge Vorteile für die Kinder. "Viele Studien zeigen, dass Kinder von älteren Eltern besser in der Schule sind, höhere geistige Fähigkeiten haben und im Alter eine spätere Sterblichkeit aufweisen", sagt der Sozialstatistiker. "Je später ein Kind geboren wird, desto besser sind die sozialen Voraussetzungen für ein Kind."
Ein weiteres Plus: Die Kinder würden meist in stabilere Familien geboren. "Ältere Eltern haben ein geringeres Risiko, sich scheiden zu lassen", so Myrskylä. Außerdem seien die Eltern auch beruflich meist etabliert. Myrskylä und Kollegen haben zudem den Glücks-Aspekt erforscht: "Wenn Menschen Kinder bekommen, sind sie einige Jahre lang glücklich, dann sinkt das Glücksgefühl wieder auf das Ausgangsniveau", so der Wissenschaftler. Bei Frauen ab 35 Jahren sei das Glücksgefühl jedoch sehr stark und halte auch langfristig an.
Klappt es mit dem Kinderwunsch nicht, sei die Enttäuschung zunächst meist sehr groß, sagt Tandler-Schneider. "Da reagieren die Paare auch mit depressiven Phasen, sind traumatisiert, einige stürzen sich in die Arbeit." Langfristig ändere sich das meist: "Durch die empirische Forschung weiß man, dass auch Paare, die keine Kinder haben, sehr glücklich miteinander sind und ein zufriedenes Alter haben. Dass man nur mit Kindern glücklich ist, ist ein Märchen."
Welches ist nun das beste Alter, sich mit dem Kinderwunsch zu beschäftigen? Aus Myrskyläs Sicht ist es "wahrscheinlich meistens eine schlechte Idee, auf den richtigen Moment zu warten". Es gebe zu viele Unsicherheiten. Sicher sei: "Wir können die Biologie nicht kontrollieren." Tandler-Schneider sagt: "Der beste Zeitpunkt für das Kinderkriegen ist daher ein möglichst zeitnaher, dies gilt vor allem für Frauen ab 35."